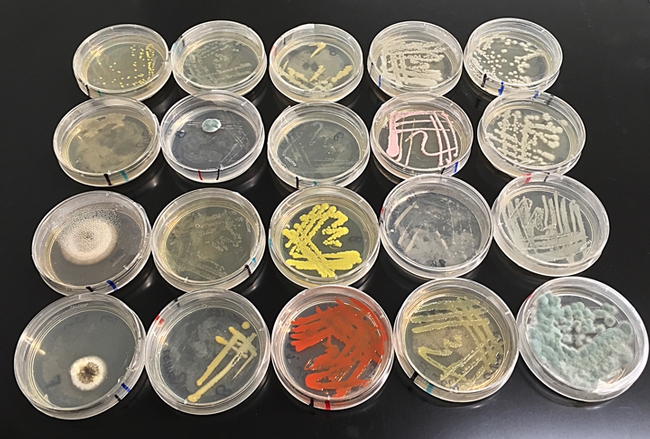

|
 |
 |
الميكروبات التي تعيش في الرحيق لها تأثير في تفضيله ليستخدم عذاء للمؤبرات
Kathy Keatley Garvey ترجمة الدكتور طارق مردود
نسمع أن نحل العسل يطن نحو زهرة؟ إنه ليس مجرد البحث عن الرحيق أو لانها عطرة.
الميكروبات التي تعيش في الرحيق تفرز روائح أو مركبات طيارة أيضا، وهذه يمكن أن تؤثر في تفضيلها كي تستخدم علفا للمؤبرات، وفقا لدراسة نشرت حديثا من قبل (جامعة كاليفورنيا في ديفيس) التي تقودها (راشيل فانيت) عالم البيئة المجتمعية.
قال Vannette، وهو أستاذ مساعد في قسم الحشرات والنيماتودا للأبحاث الرائدة، في مقالة نشرت في العدد الحالي من مجلة New Phytologist، يظهر أن الأنواع التي تقطن الرحيق من البكتيريا والفطريات يمكن أن تؤثر على المؤبرات في تفضيل الأزهار.
في دراستهم،درس الباحثون (فريق Vannette) أولا الزهور حول وجود الميكروبات التي تعيش في الرحيق، وبالتعاون مع مؤلفيk (كيتلين ريرينغ وجون بيك) من وزارة الخارجية الأمريكية - خدمة البحوث الزراعية (USDA-ARS)، غاينيسفيل، فلوريدا، خلصوا إلى وجود أربعة فطريات وبكتيريا شائعة في الرحيق. بعد ذلك، قاموا بإعدادات معقدة لقياس ردود قرون antennal وسلوك نحل العسل على المركبات الكيميائية.  جهاز تحليل الروائح والمركبات المتطايرة من رحيق الأزهار وأخيرا، عند فحص رائحة الزهور في هذا المجال، وجدوا أن الزهور التي تحتوي على كثافة عالية من الكائنات الحية الدقيقة تتضمن أيضا مركبات طيارة، المرجح أنه تنتجها تلك الميكروبات، مما يشير إلى أن إنتاج رائحة من الميكروبات يمكن الكشف عنها وتستخدم من قبل المؤبرات. وعلى الرغم من أن الميكروبات عادة تسكن رحيق الأزهار، وتختلف الأنواع الميكروبية في الأزهار المختلفة، كما وجدوا. "الكشف عن أن عسل النحل ميز معظم المواد المتطايرة الميكروبية أو الروائح التي اختبرناها"، وقال Vannette أنها تتميز بالحلول من الخمائر أو البكتيريا على أساس المتطايرة فقط". وهذا يشير إلى أن المؤبرات يمكنها الاختيار بين الزهور بناء على الميكروبات التي تعيش في تلك الزهور.
أنتجت الخميرة reukaufii Metschnikowia المركبات الأكثر تميزا (بعضها مشتركة مع نكهات الفواكه في النبيذ) وكانت أكثر جاذبية من جميع الميكروبات بالمقارنة. تم العثور على هذه الخميرة عادة في رحيق الأزهار، ويعتقد أنها تستخدم المؤبرات متطفلة للسفر من زهرة إلى أخرى. إنتاج رائحة قد تساعد على جذب المؤبرات، ومن ثم مساعدة الخميرة للنحل على التفريق بين الزهور. قدم مرفق (هاري H لايدلاو الابن) عسل النحل البحوث، جامعة كاليفورنيا في ديفيز، وعسل النحل. أكثر من 20 نوعا من الزهور - ومعظمها من الأنواع الأصليية - واستخدمت في الدراسة، بما في ذلك العائق الوادي أو بالعايق الوادي (عائق عاري الجذع)،زهرة القرد اللزجة (Mimulus aurantiacus)، المريمية (Lepechinia calycina) والمنزلية الصينية الأرجوانية(Collinsia heterophylla) . وقد أخذت العينات في الربيع وأوائل الصيف، عندما كانت المؤبرات في ذروتها. شارك في الكتابة: Co-authors of the paper are Caitlin Rering, postdoctoral fellow at USDA-ARS, Gainesville, Fla.; John Beck researcher at USDA-ARS; Griffin Hall, junior specialist in the Vannette lab; and Mitch McCartney in UC Davis Department of Mechanical and Aerospace Engineering. تأليف: كاثي كيتلي غارفي kathykeatleygarvey@gmail.com موقع: http://entomology.ucdavis.edu/ قسم الأخبار: http://ucanr.edu/blogs/entomology/ المصدر: http://ucanr.edu/blogs/bugsquad/index.cfm
|